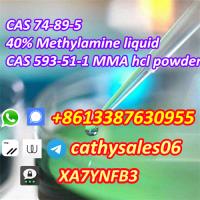

nice quality Methylamine solution 40 % 74-89-5 and Methylamine hydrochloride 593-51-1
Matanzas (Calimete)
CAS 74-89-5 40% Methylamine,CAS 593-51-1 MMA hcl
Name:Methylamine,Methylamine solution 40 %,Methylamine 40 % solution in water,Methylamine Methanolsolution,Methylamine ethanolsolution
MF:CH5N
MW: 31.06
Contact us:
WhatsApp/Signal:+8613387630955
Wickr/wire:cathysales06
Telegram:cathysales06
Threema:XA7YNFB3
1.Quality Gurantee.
2.Best price Gurantee.
3.Timely Gurantee.
4.Shipment safety Gurantee.
5.After Service Gurantee.
| No existen opiniones registradas. Opina primero acerca de este negocio o servicio. |